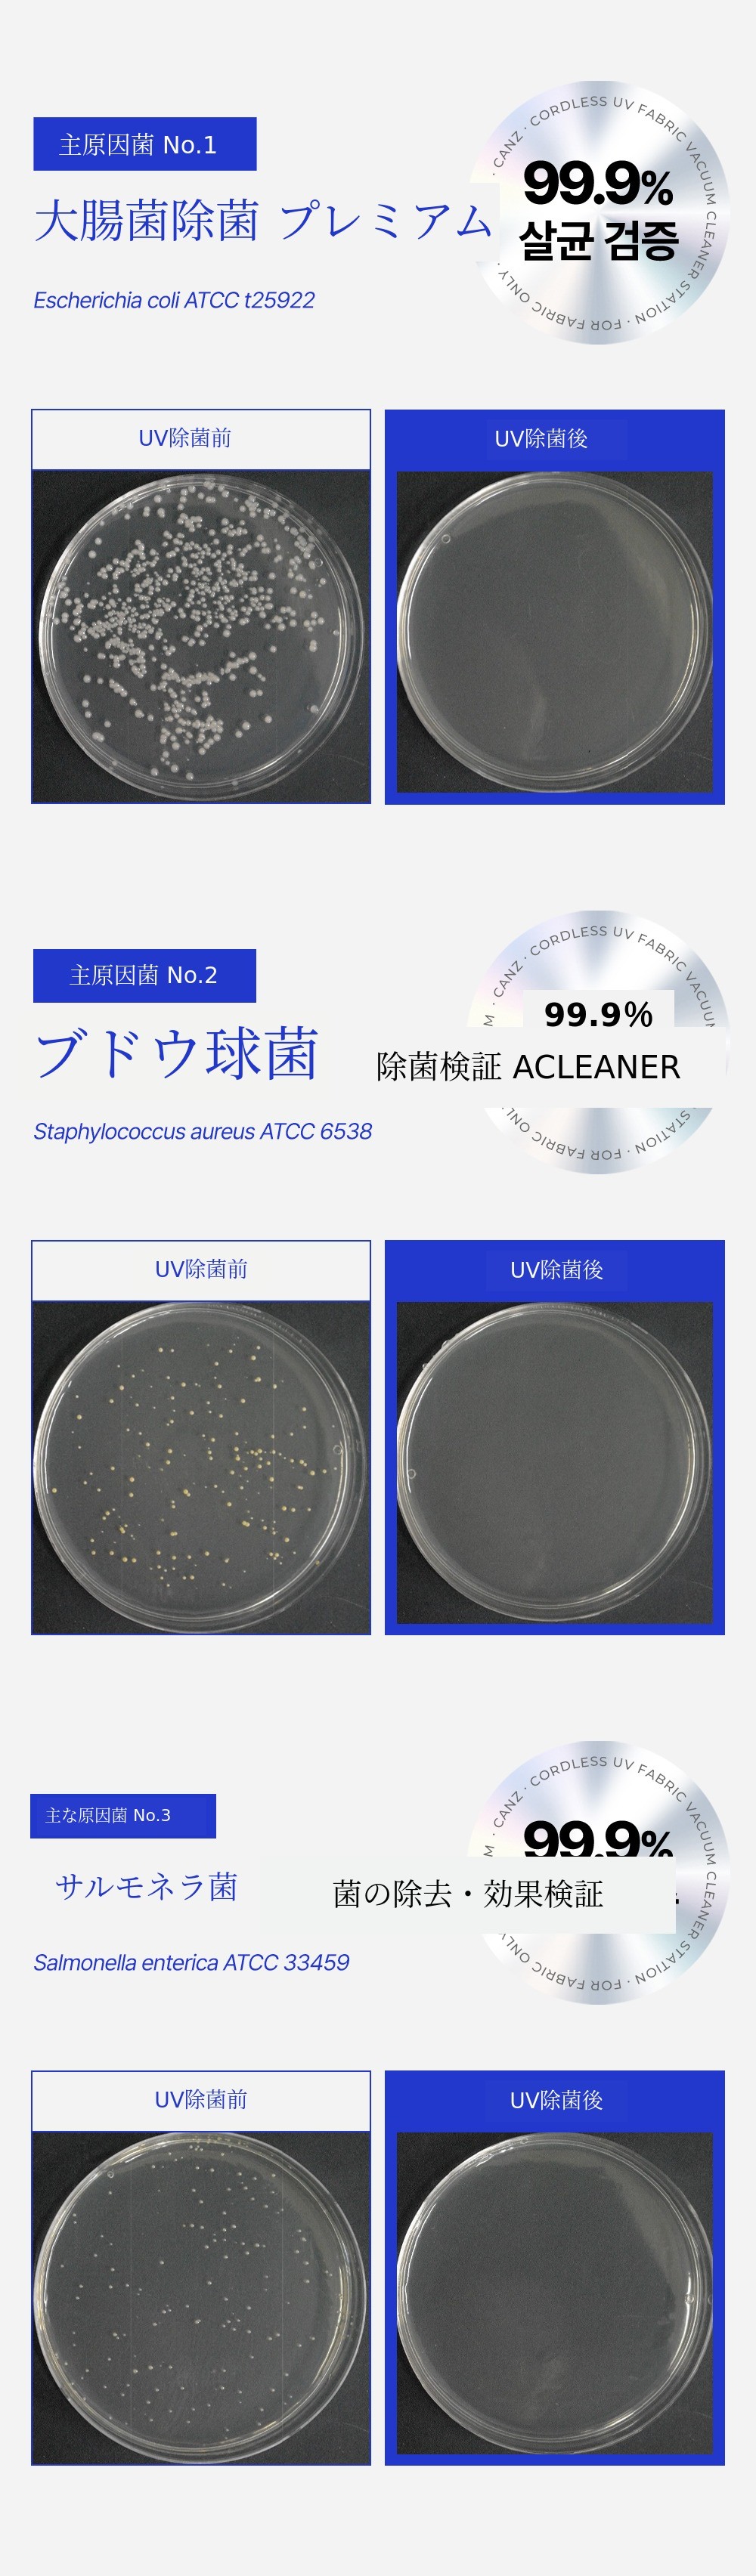

季節が変わるたび、朝起きるたびに繰り返されるくしゃみと鼻づまり。
もう10年以上もこの不便さの中で生きてきました。
もちろん、一般的な掃除機では解決できませんでした。
その経験が出発点でした。
さまざまな寝具クリーナーを実際に使い感じた限界をもとに、寝具に本当に合った構造を持つ製品を自分で開発してみようと思いました。
そうして3年間、絶えず改良を重ね、
自分で使いながら開発した成果が、今ご紹介する自動ゴミ捨て寝具クリーナーです。
特に自信を持っている機能は自動フィルター洗浄です。
髪の毛が絡まないようにフィルター構造 を何十回も修正し、
技術的に実現が難しかったですが、最終的に特許登録まで完了しました。
この一台で自動ゴミ捨て、自動フィルター洗浄、UV二重除菌 まで、
寝具掃除に必要なすべての機能を詰め込みました。
毎日寝具の上を軽く滑らせるだけで、これからは快適さが日常になります。。
もう危険な寝具のホコリ、手で触らないでください。
楽に押すだけで、毎日寝具が新品のように快適になります。
ぜひ実際にお使いいただき、快適な寝具で心地よい一日を始めて終えてください。
ありがとうございます。
なぜワディズなのですか?
7,000人を超えるサポーターの皆様が私たちを信じて共にしてくださったおかげで、
20億ウォンの累計売上と数多くのファンディング経験が可能となりました。
今回の寝具クリーナーは、そのすべての時間と努力を込めた、心からの成果物です。
だからこそ「寝具掃除の新世界」を一番に皆さんと分かち合いたかったのです。
毎日横になるその場所を快適に変えてみせます。
ぜひ一番にご参加ください!


発送方法 宅配便(1日最大発送件数:500件)
宅配会社 CJ大韓通運
送料 3,000ウォン(発送スケジュールはリワード数量によって変更される場合があり、変更時は新着情報で事前にご案内いたします。)
離島・山間地域発送案内
済州および離島・山間地域の場合、済州・離島山間地域の送料を追加でご選択ください。
製品および配送に関するお問い合わせ
-[メーカーにお問い合わせ] または Inttech7@naver.com で可能です。
-配送休業期間、すべての祝日および日曜日は配送業者が休業であることをお知らせします。
-カスタマーセンター 031-945-8695 / 相談 月〜金 10:00〜18:00
決済方法 お問い合わせ ワディズカスタマーセンター 1661-9056
A/Sカスタマーセンター 031-945-8695 / 相談時間 平日(月〜金)10:00〜18:00
1. リワード受領後7日間は製品自体の不良についてワディズ返金ポリシーが適用されます。
2. 製品の不良による成功金返金時に発生する費用は全額メーカーが負担します。
3. サポーターの故意または過失による製品の破損および紛失の場合、無償A/Sはできません。
4. 製品を組み立てたりボルトを使用した場合、返品はできません。
有料保証の場合
保証期間中でも次の場合には費用が発生します。
1. 液体の浸透または異物の吸入による損傷
2. 落下や衝撃による破損または故障
3. 揮発性溶剤(例:シンナー、ベンゼン)による外観の損傷
4. 純正部品・消耗品以外の部品による故障
5. 誤った電圧の使用
6. 未承認の分解による部品の紛失・損傷
7. 正式な承認なしに第三者による修理・改造
8. 自然災害による損傷
9. 安全指示に従わなかった場合
10. フィルター・消耗品が設置されていない状態での動作
11. 不適切な使用またはメンテナンス不足
サポーター案内
- リワードオプション・配送先・カード情報は、ファンディング締切日までマイワディズ > ファンディングする > ファンディング履歴ページで修正可能です。
- ファンディング 締切 以降 やむを得ない 理由で 配送先を 変更しなければ ならない 分は 該当 ページ 内 メーカーに お問い合わせを 通じて お問い合わせください。
 LNT tech Co.,LTD
LNT tech Co.,LTD

